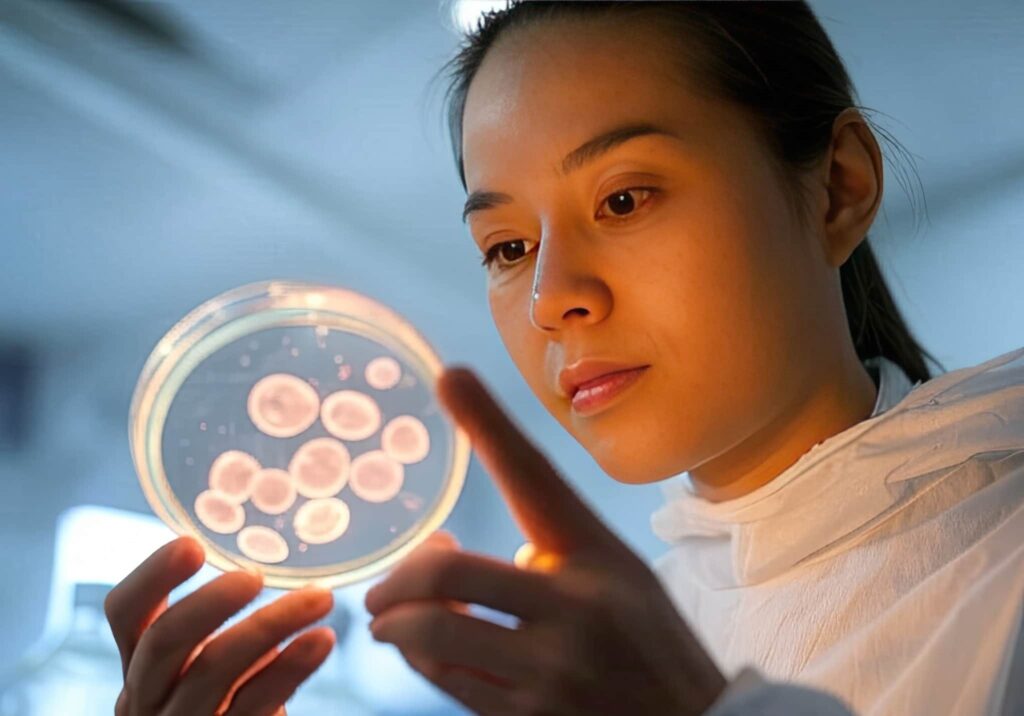

If you want to slow down time or improve recovery, we have something interesting. At VisitandMedCare, we are participating in a medical revolution. Anti-aging stem cell therapy offers hope to those seeking alternatives to cellular aging. From Turkey, we offer advanced treatments. We take advantage of this breakthrough to revitalize tissues. Our goal is clear: to help you regain the vitality that seems to be slipping away.
What is stem cell therapy?
Definition and fundamentals
Imagine cells that can be transformed into almost any tissue needed. That’s how stem cell therapy works. This treatment has great potential. These cells can become muscle, bone or nerve tissue, repairing damage over time. At VisitandMedCare, we consider them allies in the renewal of the organism. There are two main types, embryonic and adult.
Embryonic cells can become any cell. Adult cells are more specialized. They are found in bone marrow, fat and other tissues. In 2012, Shinya Yamanaka succeeded in “rewinding” adult cells into pluripotent cells. This finding earned him a Nobel Prize. This breakthrough allows for more accessible and effective treatments without ethical debates. Thanks to this, regenerative medicine is advancing.
Applications in regenerative medicine
Regenerative medicine in Istanbul demonstrates the great potential of stem cells. At VisitandMedCare, we make the most of their benefits. Can you imagine repairing a damaged heart or revitalizing worn-out joints? With tissue regeneration, we offer solutions to various diseases. We also apply stem cells to Parkinson’s disease or multiple sclerosis. In these pathologies, every advance is crucial.
We look to the future with the hope of creating organs in the laboratory for transplantation. Centers like the one in Barcelona are investigating how these cells can transform medicine. They inspire us to keep innovating.
Science is advancing fast. At VisitandMedCare, we are proud to bring it to you. Isn’t it amazing that something as small as a cell has such great potential? If you’re thinking about your health or aging with dignity, remember that we’re here to help. Perhaps the secret to feeling young is closer than you think.
Benefits of stem cells for cell regeneration and aging
Mechanisms of action in tissue regeneration
When tissues are damaged, stem cells aid in their repair. At VisitandMedCare we know that they restore the body’s ability to heal.
A key function is cell differentiation: they become what the tissue needs. They are like workers who repair damage. They also release growth factors that stimulate cell multiplication. They strengthen the surrounding tissue and accelerate healing.
They regulate the immune system, reduce inflammation and improve recovery. It’s amazing how something so small impacts wellness.
Impact on delaying aging and improving quality of life
Over time, the body shows wear and tear and its performance decreases. Senescent cells accumulate and affect tissue function.
Stem cell therapies eliminate damaged cells and restore vitality. At VisitandMedCare we apply treatments to restore lost functionality. Imagine waking up with renewed energy. Some studies, such as one in Nature, suggest that gray hair can be reversed. It’s not just aesthetics; it’s health.
Procedures available at VisitandMedCare, Turkey

Stem cell therapies for facial rejuvenation
At VisitandMedCare we help you look and feel better with cellular rejuvenation in Turkey. It’s not just about appearance, it’s about deep regeneration.
These treatments stimulate collagen, improve elasticity and reduce wrinkles. Stem cells work from the root. They achieve a natural glow that creams cannot match. Each treatment is tailored to your skin’s needs. We want the results to reflect your unique beauty.
Regenerative treatments for degenerative diseases
If you have osteoarthritis or a muscle injury, you know how frustrating the pain is. Mobility is affected. At VisitandMedCare we offer stem cell therapies to regenerate cartilage and strengthen muscles. They relieve pain and improve function.
These treatments speed recovery and reduce chronic pain. We want to restore mobility and improve your quality of life. We take pride in transforming the daily lives of our patients.
Personalized protocols and post-treatment follow-up
At VisitandMedCare we design personalized treatments for each patient. Before we start, we analyze your case and create a specific plan.
Post-treatment follow-up is key to ensure optimal results. We adjust each therapy according to the patient’s evolution. We want you to feel accompanied at all times.
Why choose Turkey for stem cell treatments?
Quality and affordability of medical services
If you want to take care of your health without spending too much, Turkey might surprise you. This country is a leader in medical tourism. At VisitandMedCare, we pride ourselves on having an outstanding infrastructure. Our hospitals and clinics have state-of-the-art technology. Every procedure is safe and effective. The best part is that costs are much lower than in Europe or the United States. That does not mean sacrificing quality. We have become a world reference in anti-aging stem cell treatments.
Experience and training of medical personnel
When it comes to health, you look for expert hands you can trust. At VisitandMedCare, our team is highly trained. Our professionals have been trained at prestigious institutions. That allows us to lead the way in regenerative medicine. Years of experience and international certifications ensure that each treatment is performed with the utmost care. We are passionate about our work. The safety and results we deliver reflect that commitment to our patients.
Testimonials from satisfied patients
Nothing makes us happier than hearing our patients tell us how their lives have changed. Many have improved their mobility. Others highlight how facial rejuvenation or chronic pain reduction has given them back their smile. The close attention we offer at VisitandMedCare makes the experience even more special.
You can check our customers’ experience on Google reviews or even on Instagram.
How to start your treatment at VisitandMedCare
Initial consultation and medical evaluation
The first contact is key, and that’s why we make it simple for you. It all starts with a consultation with a specialist. We thoroughly review your medical history. We take the time to understand your health status and history. We want to make sure treatment is feasible. Then, we design a customized plan for you. Every step is designed to achieve the best possible results.
Travel planning and accommodation
We know that traveling for treatment can seem overwhelming. At VisitandMedCare we make it easy. We help you organize your trip. We recommend comfortable accommodations near the clinic and guide you with visa and transportation. We speak your language thanks to our multilingual service. This way we avoid misunderstandings and ensure your peace of mind. We want you to feel safe from the very first moment.
Continuous contact and support during the process
From the first message to the follow-up after treatment, you are never alone. Our team is always available. We answer your questions and resolve any unforeseen issues that may arise. We strive to provide personalized attention at all times. It doesn’t stop there. We review your progress and give you tips to optimize your results. At VisitandMedCare, you are our priority.
Conclusion
Stem cell treatments are revolutionizing medicine. They open doors to cell regeneration and stem cell wellness like never before. At VisitandMedCare in Turkey, we combine cutting-edge technology, top-notch equipment and affordable prices. If you are looking for an innovative way to improve your quality of life, why not take the plunge? Schedule your WhatsApp consultation today at +90 552 935 2370 and find out how we can help you transform your health. Don’t you think you deserve to feel better?








